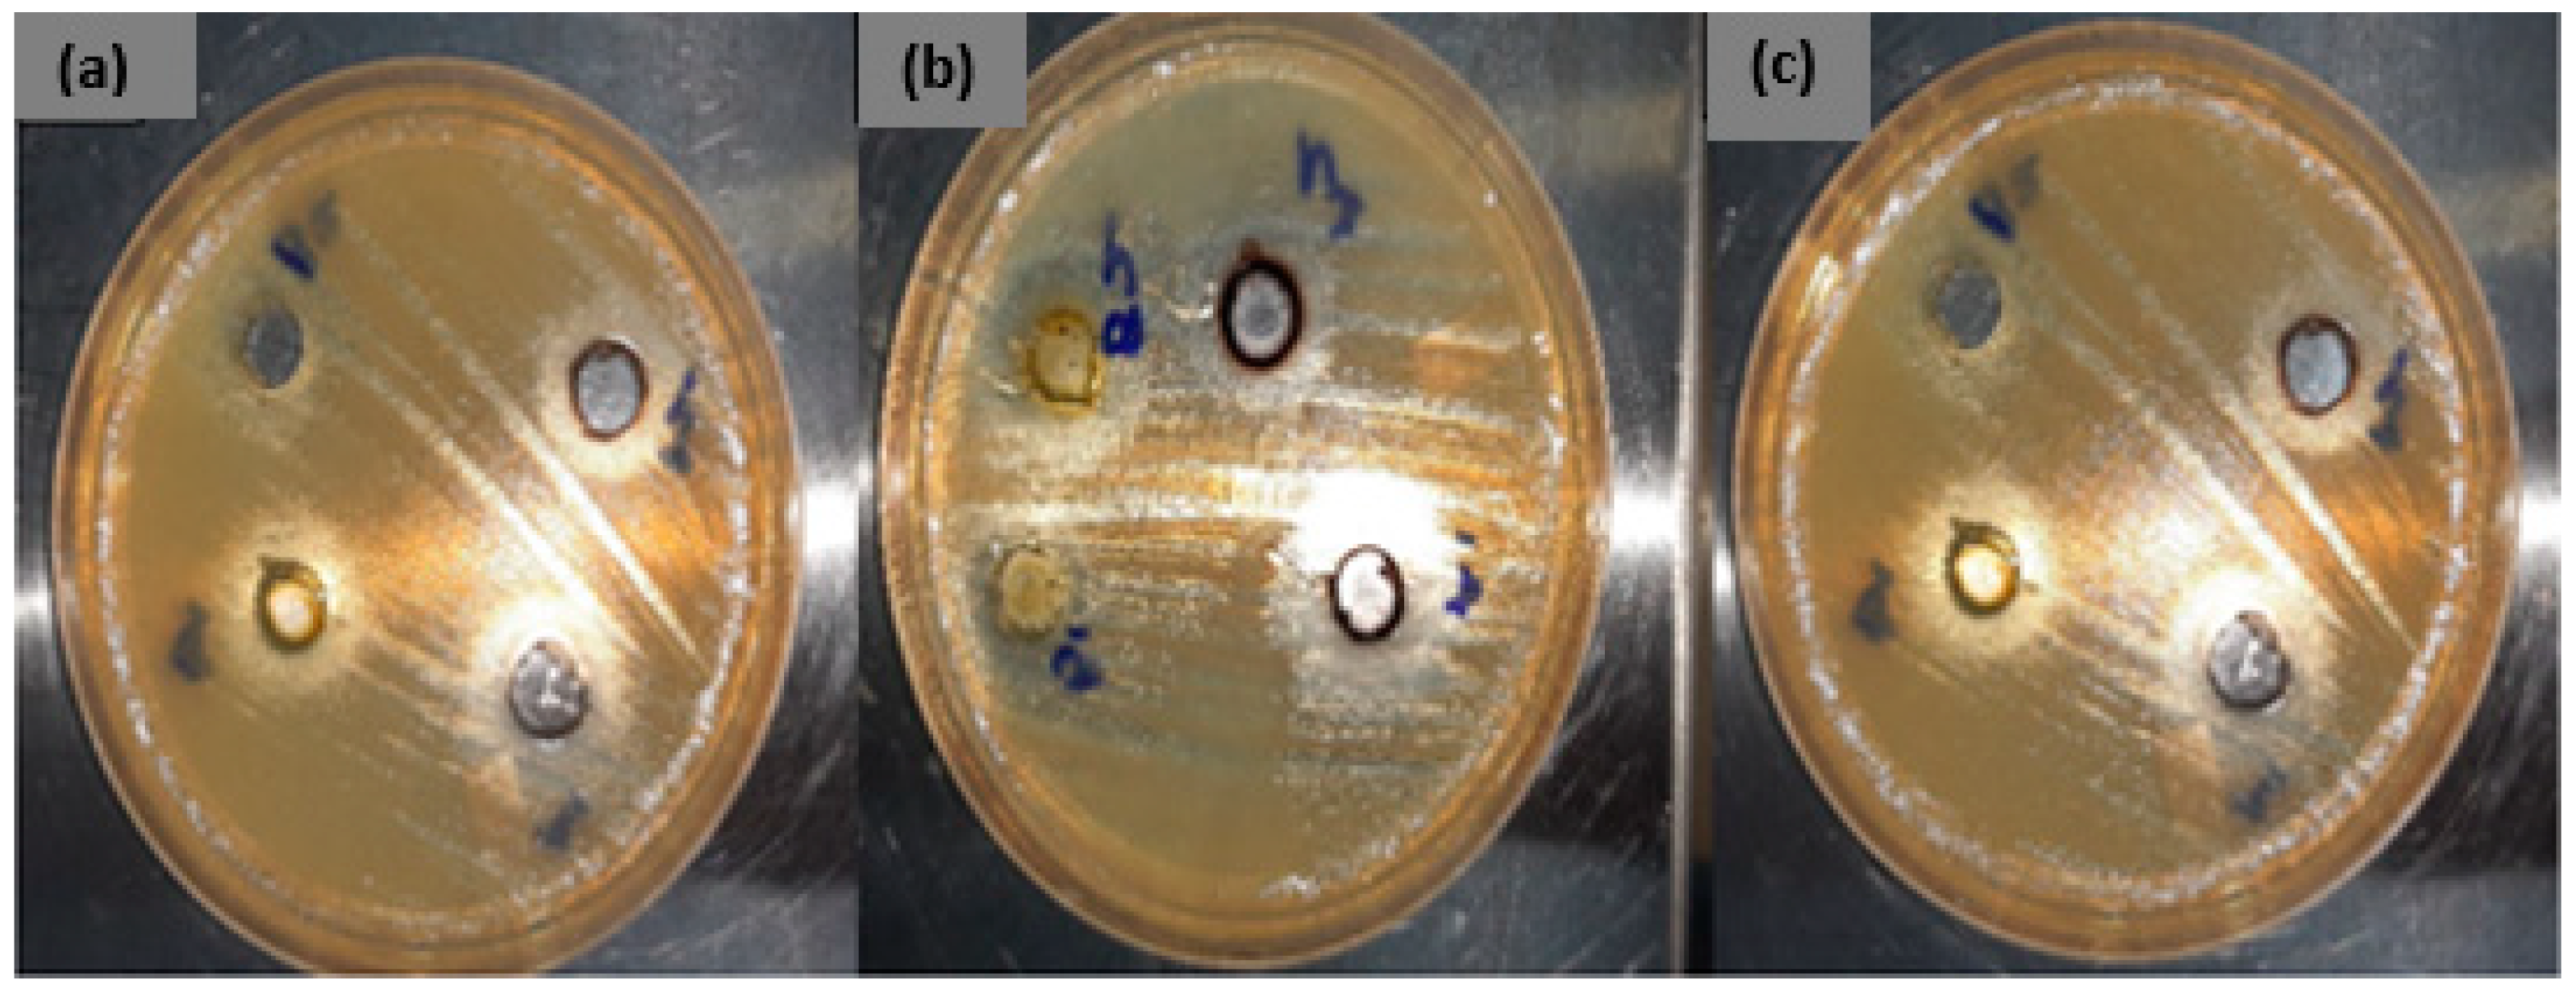
Molecules 26 00586 g009 Molecules 26 00586 g009

Spectroscopic and Antibacterial Properties of CuONPs from Orange, Lemon and Tangerine Peel Extracts: Potential for Combating Bacterial Resistance
Abstract
1. Introduction
2. Results and Discussion
2.1. Synthesis of Nanoparticles
2.2. UV-Vis
2.3. FTIR
2.4. Morphological Characterization
2.4.1. SEM
2.4.2. EDS (Energy-Dispersive X-ray Spectroscopy)
2.4.3. TEM
2.4.4. Antimicrobial Study
3. Materials and Methods
3.1. Preparation of Citrus Peel Extract
3.2. Synthesis of Copper Oxide Nanoparticles CuONPs
3.3. Characterization of the Synthesized Metal Oxide Nanoparticles
3.3.1. Spectroscopy Characterization
3.3.2. Morphological Characterization
3.3.3. Antibacterial Activity of the Synthesized CuONPs
4. Conclusions
Author Contributions
Funding
Acknowledgments
Conflicts of Interest
Sample Availability
References
- National Institute of Communicable Diseases (NICD), Antimicrobial Resistance Enterobacteriacea. 2019. Available online: http://www.nicd.ac.za/diseases-a-z-index/enterobacteriaceae (accessed on 18 February 2020).
- Pitout, J. Extraintestinal pathogenic Escherichia coli: A combination of virulence with antibiotic resistance. Front. Microbiol. 2012, 3, 9. [Google Scholar] [CrossRef] [PubMed]
- Dolan, K.T.; Chang, E.B. Diet, gut microbes, and the pathogenesis of inflammatory bowel diseases. Mol. Nutr. Food Res. 2017, 61, 1600129. [Google Scholar] [CrossRef] [PubMed]
- Roca, I.; Akova, M.; Baquero, F.; Carlet, J.; Cavaleri, M.; Coenen, S.; Cohen, J.; Findlay, D.; Gyssens, I.; Heuer, O.E.; et al. The global threat of antimicrobial resistance: Science for intervention. New Microbes New Infect. 2015, 6, 22–29. [Google Scholar] [CrossRef]
- Elder, D.P.; Kuentz, M.; Holm, R. Antibiotic resistance: The need for a global strategy. J. Pharm. Sci. 2016, 105, 2278–2287. [Google Scholar] [CrossRef] [PubMed]
- Singh, R.; Smitha, M.S.; Singh, S.P. The role of nanotechnology in combating multi-drug resistant bacteria. J. Nanosci. Nanotechnol. 2014, 14, 4745–4756. [Google Scholar] [CrossRef]
- Burt, S. Essential oils: Their antibacterial properties and potential applications in foods—A review. Int. J. Food Microbiol. 2004, 94, 223–253. [Google Scholar] [CrossRef]
- Alviano, D.; Alviano, C. Plant extracts: Search for new alternatives to treat microbial diseases. Curr. Pharm. Biotechnol. 2009, 10, 106–121. [Google Scholar] [CrossRef]
- Reichling, J.; Schnitzler, P.; Suschke, U.; Saller, R. Essential oils of aromatic plants with antibacterial, antifungal, antiviral, and cytotoxic properties—An overview. Complementary Med. Res. 2009, 16, 79–90. [Google Scholar] [CrossRef]
- Solórzano-Santos, F.; Miranda-Novales, M.G. Essential oils from aromatic herbs as antimicrobial agents. Curr. Opin. Biotechnol. 2012, 23, 136–141. [Google Scholar] [CrossRef]
- Nannapaneni, R.; Muthaiyan, A.; Crandall, P.G.; Johnson, M.G.; O’Bryan, C.A.; Chalova, V.I.; Callaway, T.R.; Carroll, J.A.; Arthington, J.D.; Nisbet, D.J. Antimicrobial activity of commercial citrus-based natural extracts against Escherichia coli O157: H7 isolates and mutant strains. Foodborne Pathog. Dis. 2008, 5, 695–699. [Google Scholar] [CrossRef]
- Karabıyıklı, Ş.; Değirmenci, H.; Karapınar, M. Inhibitory effect of sour orange (Citrus aurantium) juice on Salmonella Typhimurium and Listeria monocytogenes. Lwt-Food Sci. Technol. 2014, 55, 421–425. [Google Scholar]
- Ibrahim, H.M. Green synthesis and characterization of silver nanoparticles using banana peel extract and their antimicrobial activity against representative microorganism. J. Radiat. Res. Appl. Sci. 2015, 8, 265–275. [Google Scholar] [CrossRef]
- Pourmortazavi, S.M.; Taghdiri, M.; Makari, V.; Rahimi-Nasrabadi, M. Procedure optimization for green synthesis of silver nanoparticles by aqueous extract of Eucalyptus oleosa. Spectrochim. Acta Part A Mol. Biomol. Spectrosc. 2015, 136, 1249–1254. [Google Scholar] [CrossRef] [PubMed]
- Ahmed, S.; Ahmad, M.; Swami, B.L.; Ikram, S. A review on plants extract mediated synthesis of silver nanoparticles for antimicrobial applications: A green expertise. J. Adv. Res. 2016, 7, 17–28. [Google Scholar] [CrossRef] [PubMed]
- Kumar, P.V.; Shameem, U.; Kollu, P.; Kalyani, R.; Pammi, S. Green synthesis of copper oxide nanoparticles using Aloe vera leaf extract and its antibacterial activity against fish bacterial pathogens. BioNanoScience 2015, 5, 135–139. [Google Scholar] [CrossRef]
- Mandalari, G.; Bennett, R.; Bisignano, G.; Trombetta, D.; Saija, A.; Faulds, C.; Gasson, M.; Narbad, A. Antimicrobial activity of flavonoids extracted from bergamot (Citrus bergamia Risso) peel, a byproduct of the essential oil industry. J. Appl. Microbiol. 2007, 103, 2056–2064. [Google Scholar] [CrossRef] [PubMed]
- Kumar, V.V.; Anthony, S.P. Antimicrobial studies of metal and metal oxide nanoparticles, Surface Chemistry of Nanobiomaterials. Surface Chem. Nanobiomaterials 2016, 265–300. [Google Scholar] [CrossRef]
- Navya, P.; Daima, H.K. Rational engineering of physicochemical properties of nanomaterials for biomedical applications with nanotoxicological perspectives. Nano Converg. 2016, 3, 1. [Google Scholar] [CrossRef]
- Iravani, S. Green synthesis of metal nanoparticles using plants. Green Chem. 2011, 13, 2638–2650. [Google Scholar] [CrossRef]
- Umer, A.; Naveed, S.; Ramzan, N.; Rafique, M.S. Selection of a suitable method for the synthesis of copper nanoparticles. Nano 2012, 7, 1230005. [Google Scholar] [CrossRef]
- Korin, E.; Froumin, N.; Cohen, S. Surface analysis of nanocomplexes by X-ray photoelectron spectroscopy (XPS). Acs Biomater. Sci. Eng. 2017, 3, 882–889. [Google Scholar] [CrossRef] [PubMed]
- Zhang, L.; Gu, F.; Chan, J.; Wang, A.; Langer, R.; Farokhzad, O. Nanoparticles in medicine: Therapeutic applications and developments. Clin. Pharmacol. Ther. 2008, 83, 761–769. [Google Scholar] [CrossRef] [PubMed]
- Sharma, G.; Kumar, A.; Sharma, S.; Naushad, M.; Dwivedi, R.P.; ALOthman, Z.A.; Mola, G.T. Novel development of nanoparticles to bimetallic nanoparticles and their composites: A review. J. King Saud Univ. Sci. 2017. [Google Scholar] [CrossRef]
- Ren, G.; Hu, D.; Cheng, E.W.; Vargas-Reus, M.A.; Reip, P.; Allaker, R.P. Characterisation of copper oxide nanoparticles for antimicrobial applications. Int. J. Antimicrob. Agents 2009, 33, 587–590. [Google Scholar] [CrossRef] [PubMed]
- Padil, V.V.T.; Černík, M. Green synthesis of copper oxide nanoparticles using gum karaya as a biotemplate and their antibacterial application. Int. J. Nanomed. 2013, 8, 889. [Google Scholar]
- Meghana, S.; Kabra, P.; Chakraborty, S.; Padmavathy, N. Understanding the pathway of antibacterial activity of copper oxide nanoparticles. RSC Adv. 2015, 5, 12293–12299. [Google Scholar] [CrossRef]
- Shende, S.; Ingle, A.P.; Gade, A.; Rai, M. Green synthesis of copper nanoparticles by Citrus medica Linn. (Idilimbu) juice and its antimicrobial activity. World J. Microbiol. Biotechnol. 2015, 31, 865–873. [Google Scholar] [CrossRef]
- EL-Moslamy, H.; Shokry, H.; Rezk, H.; Abdel-Fattah, R. Bioprocess Strategies and Characterization of Anti-Multidrug Resistant Human Pathogens Copper/Copper Oxide Nanoparticles from Citrus Peel Waste Extracts. J. Nanomater. Mol. Nanotechnol 2017, 13, 21–23. [Google Scholar]
- Raffi, M.; Mehrwan, S.; Bhatti, T.M.; Akhter, J.I.; Hameed, A.; Yawar, W.; ul Hasan, M.M. Investigations into the antibacterial behavior of copper nanoparticles against Escherichia coli. Ann. Microbiol. 2010, 60, 75–80. [Google Scholar] [CrossRef]
- Pal, S.; Tak, Y.K.; Song, J.M. Does the antibacterial activity of silver nanoparticles depend on the shape of the nanoparticle? A study of the gram-negative bacterium Escherichia coli. Appl. Env. Microbiol. 2007, 73, 1712–1720. [Google Scholar] [CrossRef]
- Ehrampoush, M.H.; Miria, M.; Salmani, M.H.; Mahvi, A.H. Cadmium removal from aqueous solution by green synthesis iron oxide nanoparticles with tangerine peel extract. J. Environ. Health Sci. Eng. 2015, 13, 84. [Google Scholar] [CrossRef]
- Vincent, J.; Lekha, N.C. Bio-Engineered Copper Oxide Nanoparticles Using Citrus Aurantifolia Enzyme Extract and its Anticancer Activity. J. Clust. Sci. 2020, 1–9. [Google Scholar] [CrossRef]
- Rafique, M.; Tahir, M.B.; Irshad, M.; Nabi, G.; Gillani, S.S.A.; Iqbal, T.; Mubeen, M. Novel Citrus aurantifolia leaves based biosynthesis of copper oxide nanoparticles for environmental and wastewater purification as an efficient photocatalyst and antibacterial agent. Optik 2020, 219, 165138. [Google Scholar] [CrossRef]
- Alzahrani, E. Eco-friendly production of silver nanoparticles from peel of tangerine for degradation of dye. World J. Nano Sci. Eng. 2015, 5, 10–16. [Google Scholar] [CrossRef][Green Version]
- Shetty, S.B.; Mahin-Syed-Ismail, P.; Shaji Varghese, B.T.-G.; Kandathil-Thajuraj, P.; Baby, D.; Haleem, S.; Sreedhar, S.; Devang-Divakar, D. Antimicrobial effects of Citrus sinensis peel extracts against dental caries bacteria: An in vitro study. J. Clin. Exp. Dent. 2016, 8, 71. [Google Scholar] [CrossRef]
- Hajipour, M.J.; Fromm, K.M.; Ashkarran, A.A.; de Aberasturi, D.J.; de Larramendi, I.R.; Rojo, T.; Serpooshan, V.; Parak, W.J.; Mahmoudi, M. Antibacterial properties of nanoparticles. Trends Biotechnol. 2012, 30, 499–511. [Google Scholar] [CrossRef]
- Borkow, G.; Gabbay, J. Copper, an ancient remedy returning to fight microbial, fungal and viral infections. Curr. Chem. Biol. 2009, 3, 272–278. [Google Scholar]
- Sumitha, S.; Vidhya, R.; Lakshmi, M.S.; Prasad, K.S. Leaf extract mediated green synthesis of copper oxide nanoparticles using Ocimum tenuiflorum and its characterization. Int. J. Chem. Sci. 2016, 14, 435–440. [Google Scholar]
- Kanninen, P.; Johans, C.; Merta, J.; Kontturi, K. Influence of ligand structure on the stability and oxidation of copper nanoparticles. J. Colloid Interface Sci. 2008, 318, 88. [Google Scholar] [CrossRef]
- Honary, S.; Barabadi, H.; Gharaei-Fathabad, E.; Naghibi, F. Green synthesis of copper oxide nanoparticles using Penicillium aurantiogriseum, Penicillium citrinum and Penicillium waksmanii. Dig. J. Nanomater. Bios. 2012, 7, 999–1005. [Google Scholar]
- Sankar, R.; Manikandan, P.; Malarvizhi, V.; Fathima, T.; Shivashangari, K.S.; Ravikumar, V. Green synthesis of colloidal copper oxide nanoparticles using Carica papaya and its application in photocatalytic dye degradation. Spectrochim. Acta Part A Mol. Biomol. Spectrosc. 2014, 121, 746–750. [Google Scholar] [CrossRef] [PubMed]
- Sankar, R.; Maheswari, R.; Karthik, S.; Shivashangari, K.S.; Ravikumar, V. Anticancer activity of Ficus religiosa engineered copper oxide nanoparticles. Mater. Sci. Eng. C. 2014, 44, 234–239. [Google Scholar] [CrossRef] [PubMed]
- Alswat, A.A.; Ahmad, M.B.; Hussein, M.Z.; Ibrahim, N.A.; Saleh, T.A. Copper oxide nanoparticles-loaded zeolite and its characteristics and antibacterial activities. J. Mater. Sci. Technol. 2017, 33, 889–896. [Google Scholar] [CrossRef]
- Menazea, A. One-Pot Pulsed Laser Ablation route assisted copper oxide nanoparticles doped in PEO/PVP blend for the electrical conductivity enhancement. J. Mater. Res. Technol. 2020. [Google Scholar] [CrossRef]
- Xu, Y.Y.; Bian, C.; Chen, S.; Xia, S. A microelectronic technology based amperometric immunosensor for α-fetoprotein using mixed self-assembled monolayers and gold nanoparticles. Anal. Chim. Acta 2006, 561, 48–54. [Google Scholar] [CrossRef]
- Dhineshbabu, N.; Rajendran, V.; Nithyavathy, N.; Vetumperumal, R. Study of structural and optical properties of cupric oxide nanoparticle. Appl. Nanosci. 2016, 6, 933–939. [Google Scholar] [CrossRef]
- Nogueira, E.A.; Giroto, S.A.; Neto, B.S.A.; Ribeiro, C. CuO synthesized by solvothermal methods as a high capacity adsorbent for hexavalent chromium. Coooids Surf. A Phys. Eng. Asp. 2016, 498, 162–167. [Google Scholar] [CrossRef]
- Samat, N.A.; Nor, R.M. Sol–gel synthesis of zinc oxide nanoparticles using Citrus aurantifolia extracts. Ceram. Int. 2013, 39, 545–548. [Google Scholar] [CrossRef]
- Polat, S.; Fenercioglu, H.; Unal Turhan, E.; Guclu, M. Effects of nanoparticle ratio on structural, migration properties of polypropylene films and preservation quality of lemon juice. J. Food Process. Preserv. 2018, 42, 13541. [Google Scholar] [CrossRef]
- Al-Kalifawi, E.J. Green synthesis of magnetite iron oxide nanoparticles by using Al-Abbas’s (AS) hund fruit (Citrus medica) var. sarcodactylis swingle extract and used in Al-’alqami river water treatment. J. Nat. Sci. Res. 2015, 5, 125–135. [Google Scholar]
- Lanje, A.S.; Sharma, S.J.; Pode, R.B.; Ningthoujam, R.S. Synthesis and optical characterization of copper oxide nanoparticles. Adv. Appl. Sci. Res. 2010, 1, 36–40. [Google Scholar]
- Pendashteh, A.; Mousavi, M.F.; Rahmanifar, M.S. Fabrication of anchored copper oxide nanoparticles on graphene oxide nanosheets via an electrostatic coprecipitation and its application as supercapacitor. Electrochim. Acta 2013, 88, 347–357. [Google Scholar] [CrossRef]
- Ahamed, M.; Siddiqui, M.A.; Akhtar, M.J.; Ahmad, I.; Pant, A.B.; Alhadlaq, H.A. Genotoxic potential of copper oxide nanoparticles in human lung epithelial cells. Biochem. Biophys. Res. Commun. 2010, 396, 578–583. [Google Scholar] [CrossRef]
- Katwal, R.; Kaur, H.; Sharma, G.; Naushad, M.; Pathania, D. Electrochemical synthesized copper oxide nanoparticles for enhanced photocatalytic and antimicrobial activity. J. Ind. Eng. Chem. 2015, 31, 173–184. [Google Scholar] [CrossRef]
- Abboud, Y.; Saffaj, T.; Chagraoui, A.; El Bouari, A.; Brouzi, K.; Tanane, O.; Ihssane, B. Biosynthesis, characterization and antimicrobial activity of copper oxide nanoparticles (CONPs) produced using brown alga extract (Bifurcaria bifurcata). Appl. Nanosci. 2014, 4, 571–576. [Google Scholar] [CrossRef]
- Ahamed, M.; Alhadlaq, H.A.; Khan, M.; Karuppiah, P.; Al-Dhabi, N.A. Synthesis, characterization, and antimicrobial activity of copper oxide nanoparticles. J. Nanomater. 2014, 17, 1–4. [Google Scholar] [CrossRef]
- Mourdikoudis, S.; Pallares, R.M.; Thanh, N.T. Characterization techniques for nanoparticles: Comparison and complementarity upon studying nanoparticle properties. Nanoscale 2018, 10, 12871–12934. [Google Scholar] [CrossRef]

| CuONPs from Citrus Extract/Solvent | % Cu | % O |
|---|---|---|
| Lemon/water | 81.73 | 17.33 |
| Orange/water | 69.52 | 30.48 |
| Tangerine/water | 75.49 | 24.51 |
| Lemon/acetone | 72.62 | 27.38 |
| Orange/acetone | 39.04 | 45.27 |
| Tangerine/acetone | 66.70 | 32.83 |
| Pathogenic Bacterial Strains | Influence of Different Concentrations of CuONPs (Orange Extract) on Zone of Inhibition | |||
|---|---|---|---|---|
| (25 µg/mL) (Acetone) | (25 µg/mL) (Deionized Water) | (50 µg/mL) (Acetone) | (50 µg/mL) (Deionized Water) | |
| C. perfringens | 12 mm | 0 mm | 19 mm | 0 mm |
| C. coli | 20 mm | 0 mm | 26 mm | 0 mm |
| E. coli | 18 mm | 0 mm | 24 mm | 0 mm |
| S. aureus | 13 mm | 0 mm | 25 mm | 0 mm |
| L. monocytogenes | 0 mm | 0 mm | 0 mm | 0 mm |
| S. pneumonia | 0 mm | 0 mm | 0 mm | 0 mm |
| P. aeruginosa | 0 mm | 0 mm | 0 mm | 0 mm |
| M. catarrhalis | 7 mm | 0 mm | 16 mm | 0 mm |
| S. diarizonae | 0 mm | 0 mm | 0 mm | 0 mm |
| E. faecalis | 0 mm | 0 mm | 0 mm | 0 mm |
| Pathogenic Bacterial Strains | Influence of Different Concentrations of CuONPs (Tangerine Extract) on Zone of Inhibition | |||
|---|---|---|---|---|
| (25 µg/mL) (Acetone) | (25 µg/mL) (Deionized Water) | (50 µg/mL) (Acetone) | (50 µg/mL) (Deionized Water) | |
| C. perfringens | 0 mm | 0 mm | 0 mm | 0 mm |
| C. coli | 0 mm | 0 mm | 0 mm | 0 mm |
| E. coli | 0 mm | 0 mm | 0 mm | 0 mm |
| S. aureus | 0 mm | 0 mm | 0 mm | 0 mm |
| L. monocytogenes | 0 mm | 0 mm | 0 mm | 0 mm |
| S. pneumonia | 0 mm | 8 mm | 0 mm | 14 mm |
| P. aeroginosa | 0 mm | 0 mm | 0 mm | 0 mm |
| M. catarrhalis | 0 mm | 0 mm | 0 mm | 0 mm |
| S. diarizonae | 0 mm | 0 mm | 0 mm | 0 mm |
| E. faecalis | 0 mm | 0 mm | 0 mm | 0 mm |
| Pathogenic Bacterial Strains | Influence of Different Concentrations of CuONPs (Lemon Extract) on Zone of Inhibition | |||
|---|---|---|---|---|
| (25 µg/mL) (Acetone) | (25 µg/mL) (Deionized Water) | (50 µg/mL) (Acetone) | (50 µg/mL) (Deionized water) | |
| C. perfringens | 0 mm | 0 mm | 0 mm | 0 mm |
| C. coli | 0 mm | 16 mm | 0 mm | 25 mm |
| E. coli | 0 mm | 0 mm | 0 mm | 0 mm |
| S. aureus | 0 mm | 17 mm | 0 mm | 23 mm |
| L. monocytogenes | 0 mm | 9 mm | 0 mm | 13 mm |
| S. pneumonia | 0 mm | 0 mm | 0 mm | 0 mm |
| P. aeruginosa | 0 mm | 6 mm | 0 mm | 10 mm |
| M. catarrhalis | 0 mm | 0 mm | 0 mm | 0 mm |
| S. diarizonae | 0 mm | 0 mm | 0 mm | 0 mm |
| E. faecalis | 0 mm | 0 mm | 0 mm | 0 mm |
Publisher’s Note: MDPI stays neutral with regard to jurisdictional claims in published maps and institutional affiliations. |
© 2021 by the authors. Licensee MDPI, Basel, Switzerland. This article is an open access article distributed under the terms and conditions of the Creative Commons Attribution (CC BY) license (http://creativecommons.org/licenses/by/4.0/).
Share and Cite
Tshireletso, P.; Ateba, C.N.; Fayemi, O.E. Spectroscopic and Antibacterial Properties of CuONPs from Orange, Lemon and Tangerine Peel Extracts: Potential for Combating Bacterial Resistance. Molecules 2021, 26, 586. https://doi.org/10.3390/molecules26030586
Tshireletso P, Ateba CN, Fayemi OE. Spectroscopic and Antibacterial Properties of CuONPs from Orange, Lemon and Tangerine Peel Extracts: Potential for Combating Bacterial Resistance. Molecules. 2021; 26(3):586. https://doi.org/10.3390/molecules26030586
Chicago/Turabian StyleTshireletso, Pitso, Collins Njie Ateba, and Omolola E. Fayemi. 2021. "Spectroscopic and Antibacterial Properties of CuONPs from Orange, Lemon and Tangerine Peel Extracts: Potential for Combating Bacterial Resistance" Molecules 26, no. 3: 586. https://doi.org/10.3390/molecules26030586
APA StyleTshireletso, P., Ateba, C. N., & Fayemi, O. E. (2021). Spectroscopic and Antibacterial Properties of CuONPs from Orange, Lemon and Tangerine Peel Extracts: Potential for Combating Bacterial Resistance. Molecules, 26(3), 586. https://doi.org/10.3390/molecules26030586






